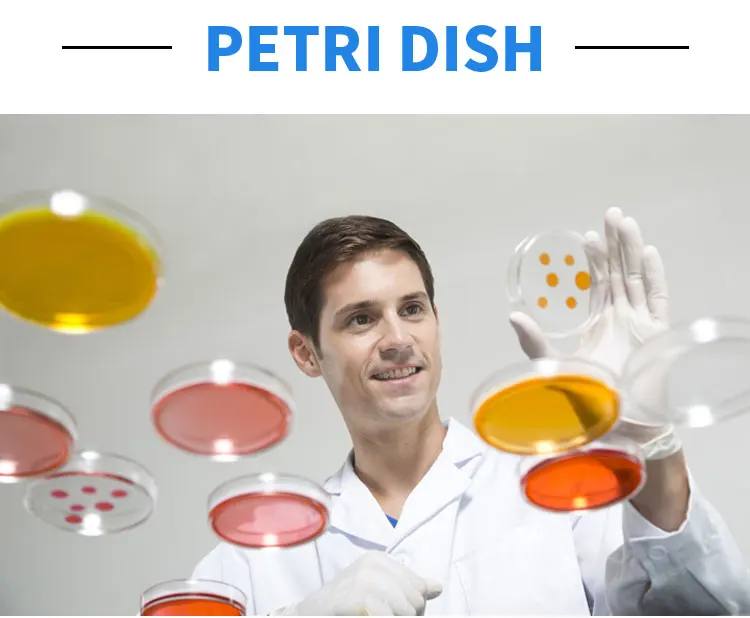

1. who are we?
We are based in Zhejiang, China, start from 2017,sell to North America(40.00%),Domestic Market(20.00%),Western Europe(10.00%),Oceania(10.00%),Eastern Europe(10.00%),South America(10.00%). There are total about 51-100 people in our office.
2. how can we guarantee quality?
Always a pre-production sample before mass production;
Always final Inspection before shipment;
3.what can you buy from us?
Medical Cotton Swab,Flocked Swab,Sampling Tube,VTM
4. why should you buy from us not from other suppliers?
Zhejiang Kangmin Medical & Healthcare Manufacturing Co.,Ltd is located in Lanxi,China.Founded in 2017, well known as a manufacturer of swabs and other disposable medical consumables products for healthcare.
5. what services can we provide?
Accepted Delivery Terms: FOB,CFR,CIF,EXW,DDP,Express Delivery;
Accepted Payment Currency:USD,EUR,JPY,CAD,AUD,HKD,GBP,CNY,CHF;
Accepted Payment Type: T/T,L/C,MoneyGram,Credit Card,PayPal,Western Union,Cash;
Language Spoken:English,Chinese